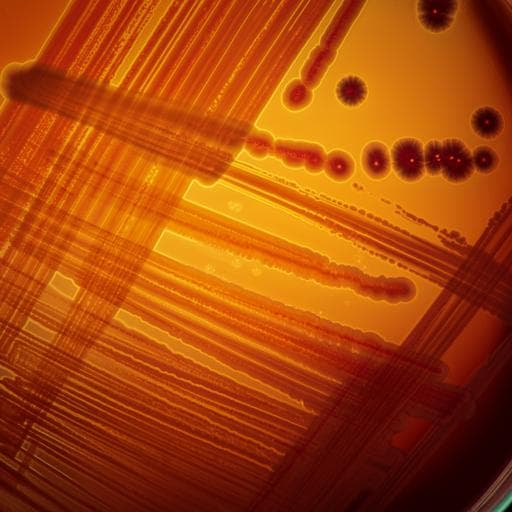
The need for high-resolution gut microbiome characterization to design efficient strategies for sustainable aquaculture production

Veterinary Science
The need for high-resolution gut microbiome characterization to design efficient strategies for sustainable aquaculture production
S. Gupta, A. V. D. León, et al.
This fascinating study delves into the effects of microbiota-directed fibers in Atlantic salmon, uncovering how varying dietary inclusions influence gut microbiome composition. Despite a notable shift at a higher dose, the research reveals minimal impacts on host gene expression and highlights the need for advanced microbiome characterization. Conducted by a diverse team of researchers including Shashank Gupta and Arturo Vera-Ponce de León, this work paves the way for future interventions targeting lactic acid bacteria.
Playback language: English
Related Publications
Explore these studies to deepen your understanding of the subject.